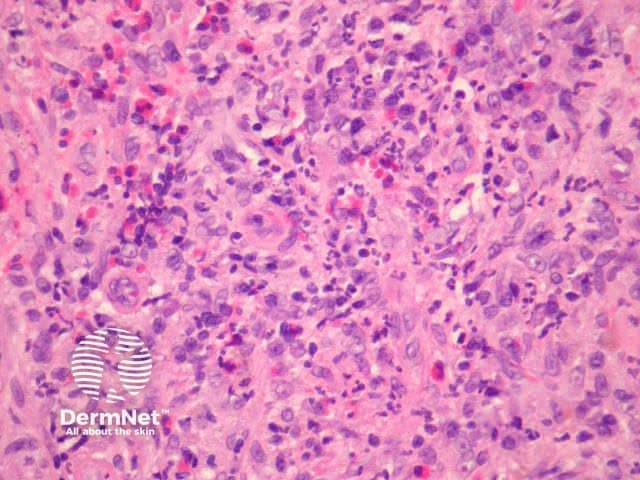
Figure 5

Main menu
Common skin conditions
NEWS
Join DermNet PRO
Read more
Quick links
Blood vessel problems Diagnosis and testing
Author: Dr Harriet Cheng, Dermatologist, Waikato Hospital, Hamilton, New Zealand; Dr Duncan Lamont, Pathologist, Hamilton, New Zealand; Patrick Emmanuel, Dermatopathologist, Auckland, New Zealand, 2013.
Erythema elevatum diutinum is a rare chronic dermatosis characterised by red-brown papules and nodules often on the dorsal hands and other extensor surfaces. The skin lesions may be associated with systemic symptoms such as arthralgia, and associations with haematological and rheumatological conditions have been reported.
In erythema elevatum diutinum, there is sparing of the papillary and periadnexal dermis (Figures 1, 2). Vascular infiltration in the upper and mid-dermis with predominant neutrophils and fewer lymphocytes, eosinophils and plasma cells (Figures 3, 4, 5). Leucocytoclasia is commonly seen in fresh lesions (Figure 5). Later lesions develop sclerosis with plasma cells and residual foci of leukocytoclastic vasculitis. Sclerosis may be striking and have a storiform pattern (Figures 1, 4).

Figure 1

Figure 2

Figure 3

Figure 4
Figure 5
Granuloma faciale — this is thought by some authorities to represent the same disorder but involving the face. Both appear to represent a sclerosing small vessel vasculitis. Granuloma faciale is less likely to be associated with systemic disease.
Leukocytoclastic vasculitis — acute forms have less infiltrate and more erythrocyte extravasation.
Acute neutrophilic dermatosis — although clinically distinct, early lesions of erythema elevatum diutinum may resemble Sweet syndrome and other neutrophilic dermatoses.
Dermatofibroma — later fibrotic stages of erythema elevatum diutinum may mimic dermatofibroma but lack peripheral collagen entrapment and epidermal hyperplasia.
Eosinophilic angiocentric fibrosis — characterised by fibrosis (which may be storiform) surrounding small arteries of the orbit and upper respiratory tract. Mixed inflammatory infiltrates with predominant eosinophils. Recently an association with increased IgG4 has been reported.